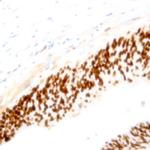
Cyclin B1 Antibody in Immunohistochemistry (Paraffin) (IHC (P))

Search
AbboMax
Cyclin B1 Polyclonal Antibody
{{$productOrderCtrl.translations['antibody.pdp.commerceCard.promotion.promotions']}}
{{$productOrderCtrl.translations['antibody.pdp.commerceCard.promotion.viewpromo']}}
{{$productOrderCtrl.translations['antibody.pdp.commerceCard.promotion.promocode']}}: {{promo.promoCode}} {{promo.promoTitle}} {{promo.promoDescription}}. {{$productOrderCtrl.translations['antibody.pdp.commerceCard.promotion.learnmore']}}
图: 1 / 1
Cyclin B1 Antibody (500-4104) in IHC (P)
产品信息
500-4104
种属反应
宿主/亚型
分类
类型
抗原
偶联物
形式
浓度
规格
纯化类型
保存液
内含物
保存条件
运输条件
产品详细信息
Positive control: Carcinoma
Cellular location: Cytoplasm, Nucleus.
靶标信息
Cyclins bind to and regulate the activity of the Cyclin dependent protein kinases (CDKs). Cyclin B1 or CCNB1 is a regulatory protein involved in mitosis. It is essential for the control of the cell cycle at the G2/M transition. Cyclin B1 complexes with p34 (cdc2) to form the maturation-promoting factor (MPF). Two alternative transcripts have been found, a constitutively expressed transcript and a cell cycle-regulated transcript, that is expressed predominantly during G2/M phase. Cyclin B1 is not ubiquitinated during G2/M phase, resulting in its steady accumulation during G2 phase, followed by abrupt APC dependent destruction at the end of mitosis. Destruction of Cyclin B1 is required for cell cycle progression. Cyclin B1 is overexpressed in various cancers, including breast, prostate, and non-small cell lung cancer.
仅用于科研。不用于诊断过程。未经明确授权不得转售。
篇参考文献 (0)
生物信息学
蛋白别名: cyclin B1, related sequence 1; cyclin B1, related sequence 13; G2/mitotic-specific cyclin B1; G2/mitotic-specific cyclin-B1; OTTHUMP00000221981; OTTHUMP00000223023; unnamed protein product
基因别名: Ccn-2; CCNB; CCNB1; Ccnb1-rs1; Ccnb1-rs13; Cycb; Cycb-4; Cycb-5; CycB1; Cycb1-rs1
UniProt ID: (Human) P14635, (Rat) P30277, (Mouse) P24860
Entrez Gene ID: (Human) 891, (Rat) 25203, (Mouse) 268697




